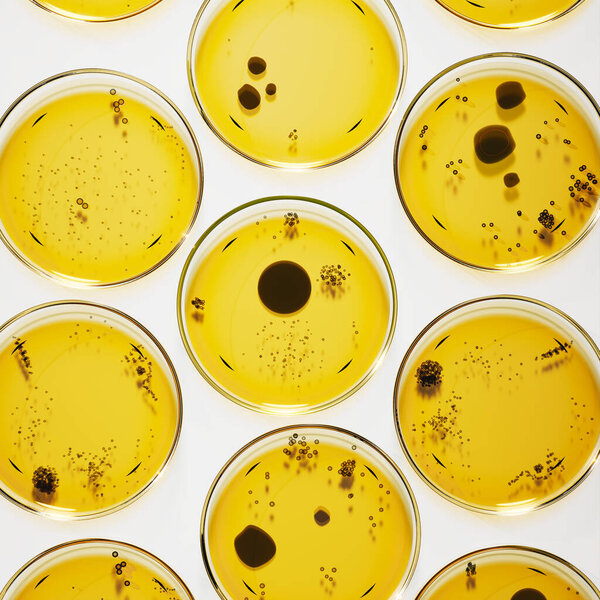
This captivating image showcases rows of Petri dishes containing a circular flat form of black bacterial or fungi colonies. Yellow agar plate used to diagnose infection. Microbiology, laboratory

- /
- Search /
- Growing Bacteria in Petri Dishes.
Growing Bacteria in Petri Dishes.
Growing Bacteria in Petri Dishes on agar gel as a part of scientific experiment. Macro shot.
image
image
Jun.16, 2015 03:57:07
7.94
1.00
500x500
1000x1000
2000x2000
2817x2817
2817x2817
135
9
kasto
GREEN BACKGROUND MACRO GLASS TRANSPARENT DETAIL GROWTH MICRO GROW PATTERN PLATE MEDICINE MEDICAL DISH TECHNOLOGY BIOLOGICAL CELL CULTURE BIOLOGY EXPERIMENT LABORATORY SCIENCE FUNGUS VIRUS BACTERIUM RESEARCH ANALYSIS SCIENTIFIC MICROBE ORGANISM BIO FUNGI ANALYZE BIOCHEMISTRY BACTERIA SWAB MICROBIOLOGY COLONY STRAIN INFECTIOUS PATHOGEN PATHOLOGY GRAFT PETRI AGAR BACTERIOLOGY HEALTH CARE PETRI DISH MICRO ORGANISM AGAR PLATE